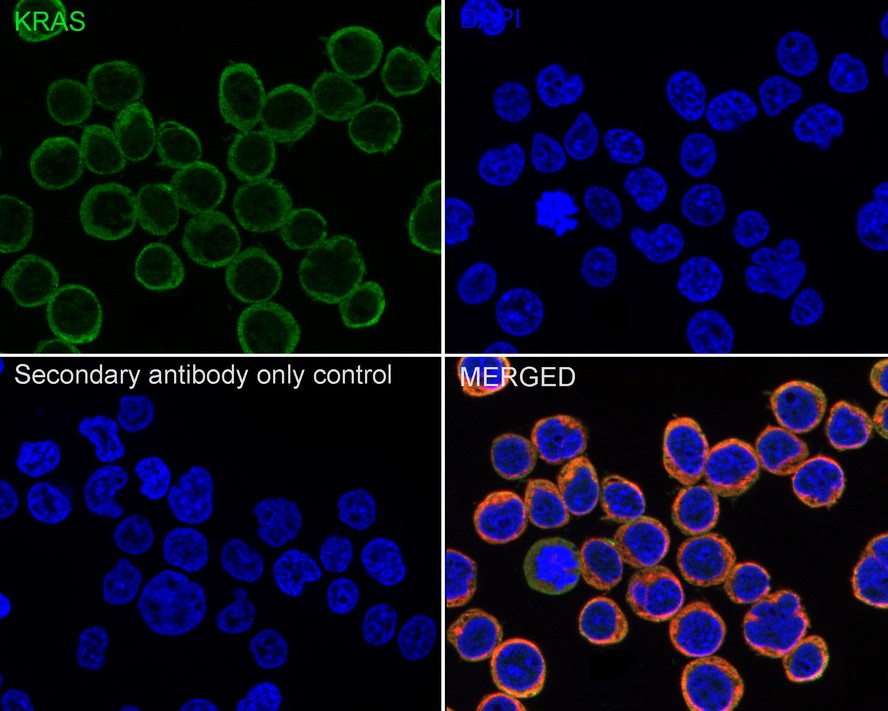

Catalog# HA601059
KRAS Mouse Monoclonal Antibody [A8E5]
Application
-
WB
-
IF-Cell
-
IHC-P
-
FC
Reactivity
-
Human
-
Mouse
-
Rat
Conjugation
-
unconjugated
This product has been cited in peer reviewed publications, see list HERE

浙公网安备 33019202000643号
浙公网安备 33019202000643号